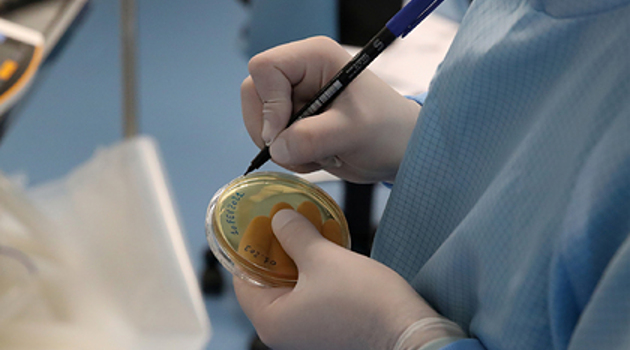
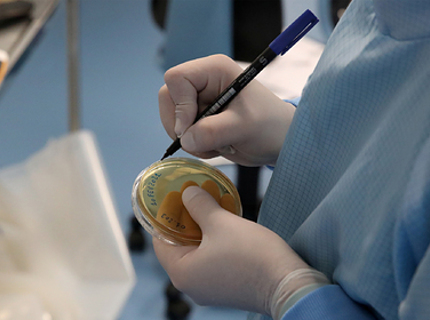

Все материалы за 24 марта 2021
Март
пн
вт
ср
чт
пт
сб
вс

Неизвестный штамм COVID-19 обнаружен в Европе
Коронавирус8

Короставник полевой: лекарственные свойства
Новости медицины

Почему не получается сбить температуру
Новости медицины

О каких болезнях расскажут ногти
Новости медицины

Как правильно пить таблетки, чтобы не навредить себе
Новости медицины
Новости партнеров